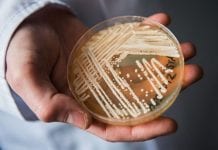
Groźny grzyb, którym się można zarazić w szpitalu

Arktyka płonie
W Arktyce szaleją pożary, ale rząd federalny mówi, że ten rok jest przeciętny. Przynajmniej w Kanadzie. Naukowcy są innego zdania, według nich sytuacja jest...
Energetyka wiatrowa i słoneczna – czy to ma sens?
Fraser Institute opublikował raport dotyczący opłacalności energii odnawialnej zatytułowany „Generating Electricity in Canada from Wind and Sunlight: Is Getting Less for More Better than...
Fałszywe gazety z Quebecu zarabiają na reklamach Google’a
Dwa portale internetowe, podające się za strony gazet z Quebecu, w rzeczywistości są sterowane z Ukrainy. Strony Koz Times i Gal Post wyglądają bardzo...
Ambasada w Hawanie przywraca część usług
Ambasada Kanady w Hawanie przywraca część usług wizowych. Od 1 sierpnia Kubańczycy, którzy będą musieli zostawić swoje odciski palców i będą potrzebowali zdjęcia paszportowego,...
W Ontario spada zainteresowanie samochodami elektrycznymi
Po zwycięstwie w wyborach ontaryjscy konserwatyści stwierdzili, że subsydiowanie samochodów dla bogatych, którzy mogą wydać parę tysięcy więcej na samochód elektryczny, nie ma sensu...
Gratka dla łowców meteorytów
Royal Ontario Museum zwraca się do poszukiwaczy meteorytów o pomoc w odnalezieniu fragmentów meteorytu, który rankiem w środę wszedł w atmosferę nad Bancroft, Ont....
Klimatyczny stan wyjątkowy to fikcja
Radni North Vancouver i West Vancouver ogłosili niedawno klimatyczny stan nadzwyczajny. Jedni i drudzy byli w tej decyzji jednogłośni. Pytanie, czy decyzja nie została...
Zapominamy o aferze SNC-Lavalin
Z najnowszego badania opinii publicznej przeprowadzonego na zlecenie Canadian Press wynika, że Kanadyjczycy zaczynają zapominać o sprawie SNC-Lavalin. Notowania liberałów poprawiają się. 33 proc....
Groźny grzyb, którym się można zarazić w szpitalu
Lekarze i naukowcy szukają sposobów walki ze stosunkowo niedawno odkrytym patogenem grzybiczym Candida auris, który jest obecny również w Kanadzie. Został zidentyfikowany w 2009...
Czy w Kanadzie zabraknie leków?
Perspektywa najazdu Amerykanów na kanadyjskie apteki po zakup tańszych leków na receptę każe niektórym straszyć widmem niedoborów leków na północ od granicy z USA.
W...